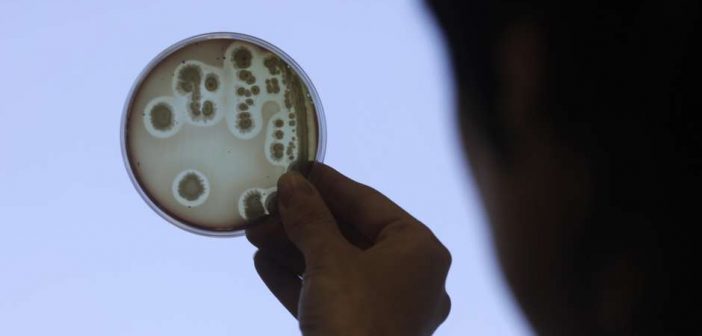

Ciência cria 1º ser 100% editado e sintético
Sintetização de material genético em laboratório levou à criação de organismo mais ‘enxuto’; pesquisa abre caminho para novas tecnologias
Cientistas conseguiram reconstruir e sintetizar, pela primeira vez, todo o DNA de um organismo vivo em laboratório. Trata-se da bactéria Escherichia coli, que habita o intestino humano, e ganhou um novo “design” genético. O estudo, realizado por pesquisadores do Laboratório de Biologia Molecular, no Reino Unido, é mais um passo no campo da biologia sintética e pode dar pistas para avanços que vão desde tratamentos de doenças genéticas até ações de combate à poluição.
Comparando com um livro, é possível dizer que o código genético pode ser escrito com apenas quatro letras, batizadas de A, T, G e C. Combinadas em trios, essas letras formam “palavras”, os aminoácidos, que, juntos, formam as proteínas.
Há 64 combinações possíveis para esses trios de letras (chamados na Biologia de códons), mas apenas 20 aminoácidos no mundo. Essa discrepância levou os cientistas a tentar decifrar quais dessas “palavras” poderiam ser trocadas por outras já usadas sem prejuízo para a formação das células.
Eles conseguiram reduzir de 64 para 61 o número de trios de letras usados. Para isso, tiveram de fazer mais de 18 mil trocas de códons redundantes. Ao reescrever o código genético inteiro da bactéria com a ajuda de um computador, obtiveram um “manual” do tamanho mesmo de um livro, dos grandes, com dezenas e dezenas de páginas. Foi com esse roteiro em mãos que eles produziram quimicamente as substâncias e as encaixaram pouco a pouco.
O resultado foi surpreendente: o processo deu origem a uma bactéria geneticamente mais enxuta, que conseguiu sobreviver. Batizado de Syn61 – em referência ao novo número de códons -, o organismo de laboratório tem um desenvolvimento apenas um pouco mais lento do que o original. A pesquisa, publicada na revista científica Nature, é inovadora porque, até então, outros estudos mostraram ser possível sintetizar o DNA de uma bactéria, mas sem editá-lo completamente para uma versão mais reduzida.
Além disso, nunca houve antes uma sintetização de DNA tão extensa. “Até onde sabemos, a escala de substituição genômica na Syn61 é aproximadamente quatro vezes maior do que a relatada anteriormente”, escreveram os autores. Agora, os pesquisadores querem entender melhor as consequências do novo design e investigar novas formas de recodificação.
Aplicações
Para Mayana Zatz, geneticista e pesquisadora da Universidade de São Paulo (USP), o estudo pode dar pistas para novas descobertas até mesmo na área da Medicina.
“Para quem trabalha, como eu, com doenças genéticas, saber que se pode deletar códons e ainda ter um gene funcional pode ser importante. Ajuda a entender melhor quais os códons essenciais e quais podem ser deletados sem consequências”, diz Mayana. “Existem doenças genéticas em que há uma expansão de sequências de DNA. Uma das estratégias que se pensa é poder deletar sequências que estão a mais.”
Imagina-se que a Escherichia coli redesenhada possa ficar mais protegida contra a invasão de alguns tipos de vírus – e essa característica também pode ajudar em pesquisas sobre doenças e tratamentos.
Por outro lado, a reprodução dos organismos não traz risco à saúde, já que a bactéria é abundante na natureza e está até na flora intestinal. Para Mayana, o estudo abre o campo para sintetizar outros organismos. “Bactérias que poderiam destruir, por exemplo, o petróleo jogado no mar. Podemos pensar em inúmeras utilidades.”
O campo da biologia sintética vem despertando interesse nos últimos anos por suas aplicações práticas. Hoje, já são desenvolvidos organismos modificados para a produção de substâncias sintéticas como a insulina, considerada até mais eficaz.